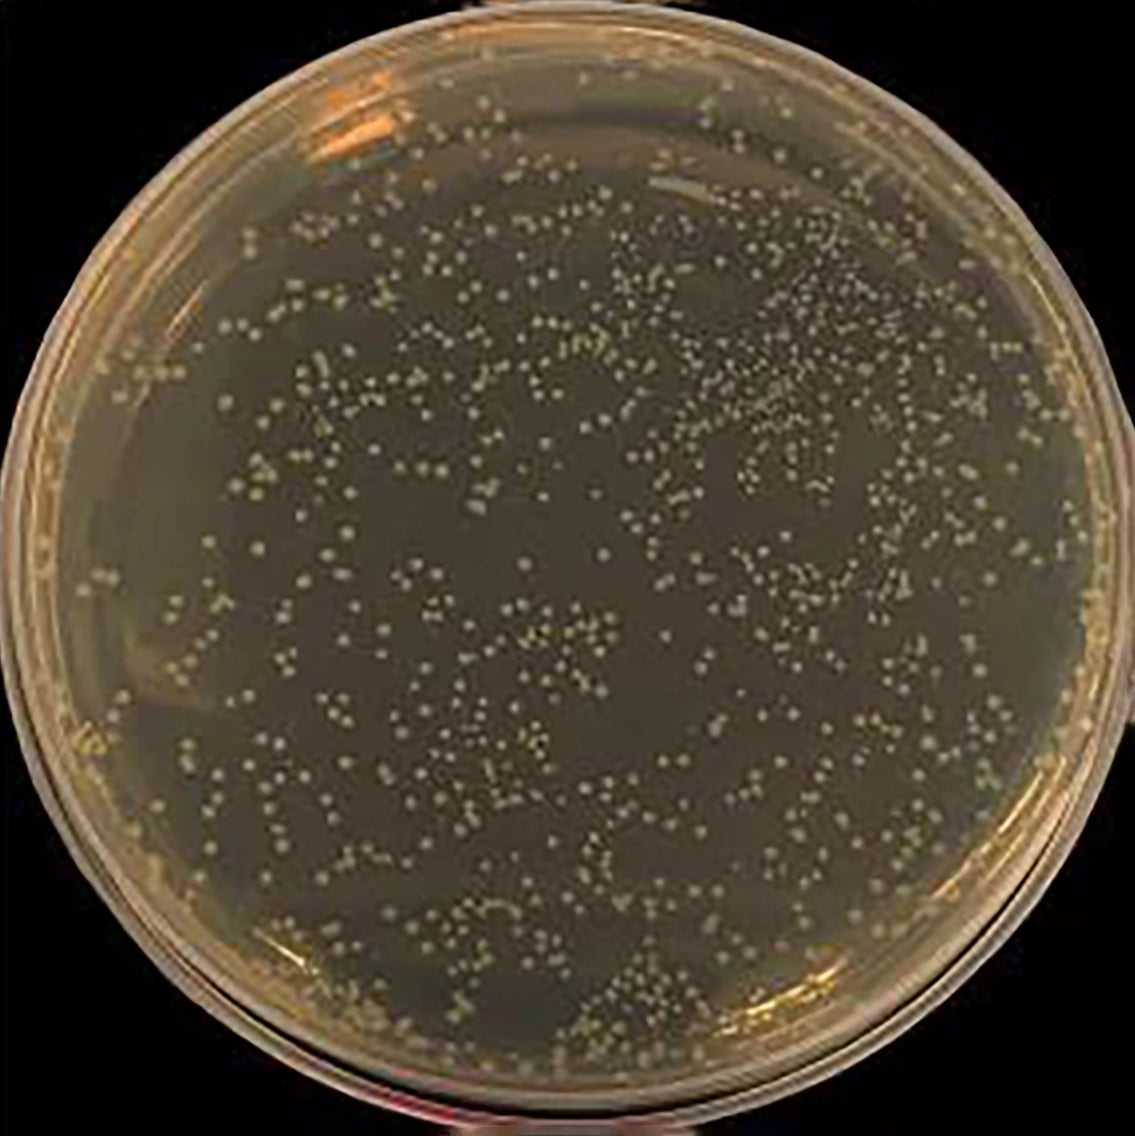
Silver Containing 316L Stainless Steel Injection Molding Products Are Antibacterial
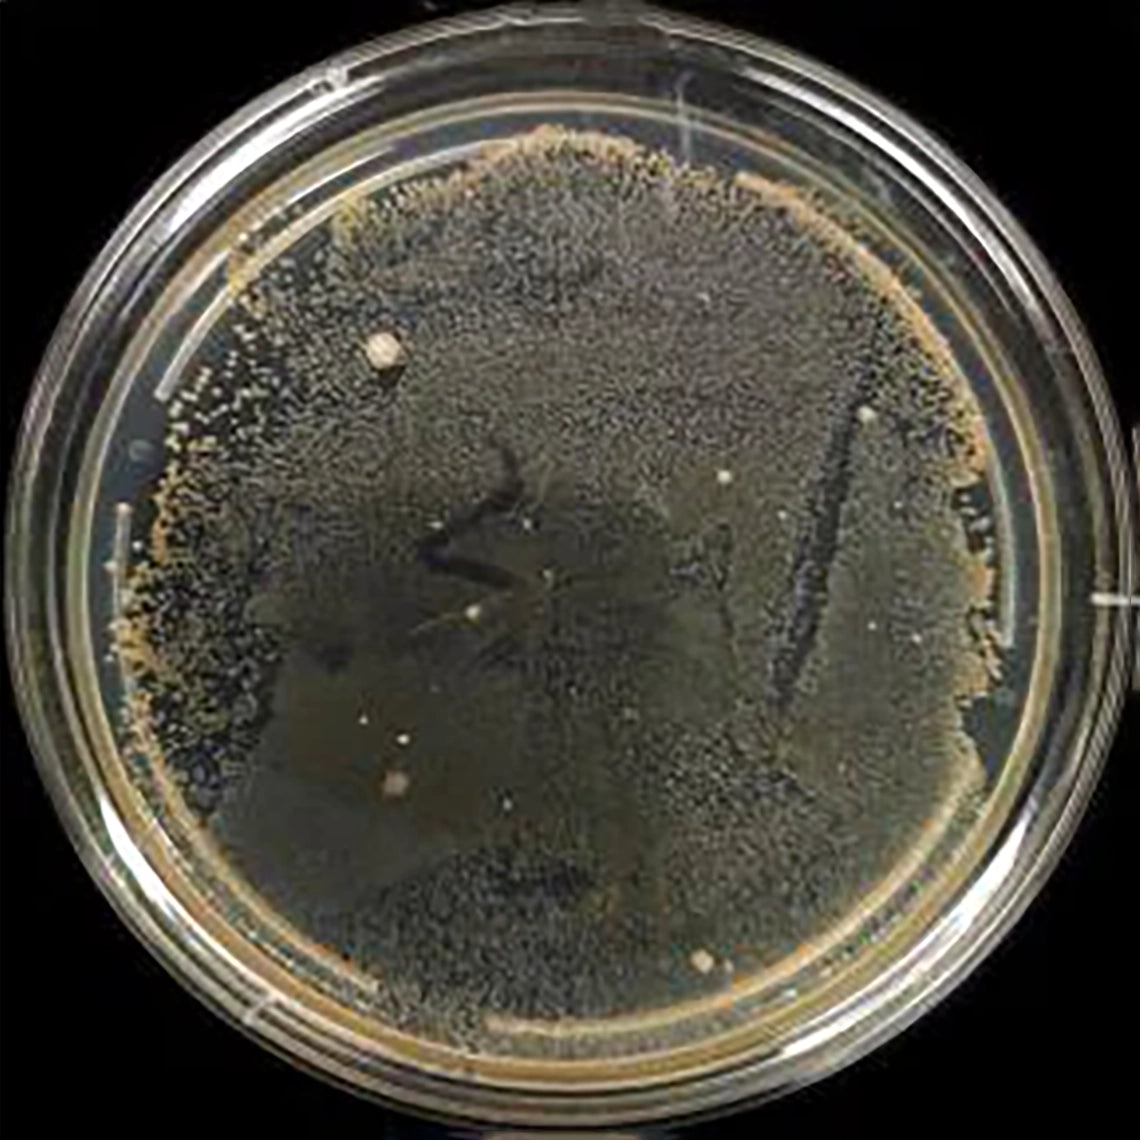
Silver Containing 316L Stainless Steel Injection Molding Products Are Antibacterial

MIM Parts for Medical Device
We work with professional medical manufacturers to provide components for surgical tools, telemedicine devices, diagnostic systems, and dental equipment. They choose XY-GLOBAL because we deliver the precision and design flexibility they need—supported by advanced processes such as Metal Injection Molding (MIM) for complex and miniaturized parts.
Medical Related Case Studies

Endoscopic Devices
Our expertise in Metal Injection Molding (MIM) enables us to produce custom, high-precision endoscopic devices that meet the rigorous demands of the medical industry. We provide complex, biocompatible components for laparoscopic instruments with tolerances as precise as ±0.001mm.
Our production capabilities ensure consistent quality and reliability, enabling medical device manufacturers to innovate and optimize their products, and from design consultation to mass production, we are committed to supporting the development of cutting-edge medical solutions.

Robotic Surgical Tools
Our advanced Metal Injection Molding (MIM) technology produces robotic surgical tools with exceptional precision and reliability.
We specialize in manufacturing complex, biocompatible components to meet the rigorous requirements of cutting-edge robotic surgical systems.
From complex design to volume production, our solutions support the innovation and performance of next-generation robotic surgical tools.

Life Science Analyzers
We are committed to supporting the life sciences industry with precision manufacturing that meets the most stringent requirements. Our ISO 13485 certification ensures compliance with medical-grade standards, guaranteeing product reliability and safety.
With a controlled production environment and advanced equipment, we deliver biocompatible, high-precision components tailored to the demands of life sciences and medical technologies.
Surgical Tools
Biocompatible Medical Devices
Surface Finish for Medical Implants

ISO 13485:2016 Certified
Healthcare leaders choose XY-GLOBAL as a trusted medical equipment parts supplier because we are ISO 13485–certified and ensure every prototype and component meets full regulatory requirements. Our strong quality system and advanced capabilities—including Metal Injection Molding (MIM)—enable us to deliver precise, reliable parts for dental devices, surgical tools, biotechnology products, and more.
Antibacterial Stainless Steel
MIM Supplier uses silver-containing 316L stainless steel made by powder metallurgy to solve the engineering problem of silver-iron incompatibility. The microstructure shows that silver nanoparticles are uniformly distributed in the stainless steel matrix, resulting in good broad-spectrum antibacterial properties.

MIM Technical Support & Traceability
With a team of experienced engineers, we provide comprehensive technical support and after-sales service to address any challenges during use. Additionally, we ensure full traceability throughout the metal or ceramic injection molding process, providing proof of origin (COA) and detailed records for every production stage.